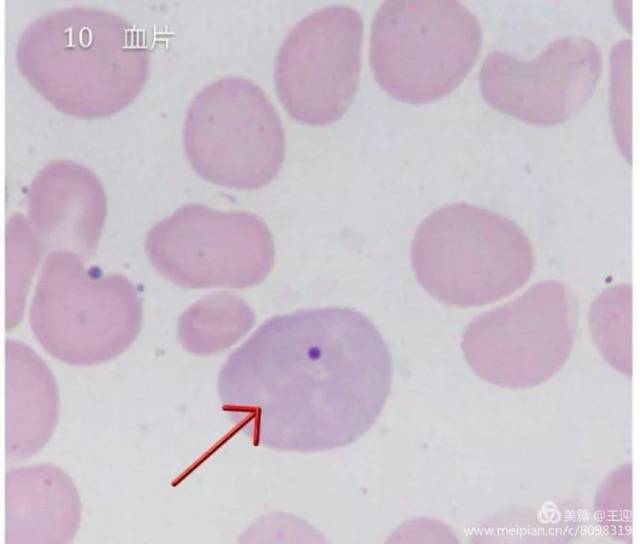
10.含有howell-jolly 小体的嗜多色性大红细胞
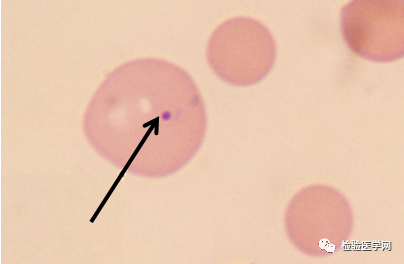
巨红细胞(直径>15um),大红细胞(直径10-15um).

大红细胞

大红细胞
图片尺寸2667x2000
红细胞
图片尺寸1200x805
巨红细胞(直径大于15μm,常见病同大红细胞);大红细胞(直径大于10μm
图片尺寸900x675
不同寻常的大细胞性贫血探因之路
图片尺寸800x526
巨红细胞(直径>15um),大红细胞(直径10-15um).
图片尺寸362x265
正常红细胞
图片尺寸1200x827
正常红细胞
图片尺寸1200x800
主管检验技师辅导高色素性红细胞
图片尺寸396x297
(图) 正常红细胞
图片尺寸1140x818
红细胞
图片尺寸1200x799
红细胞.
图片尺寸1200x600
红细胞
图片尺寸658x411
10.含有howell-jolly 小体的嗜多色性大红细胞
图片尺寸640x544
红细胞
图片尺寸413x324
巨红细胞(直径>15um),大红细胞(直径10-15um).
图片尺寸335x248
红细胞
图片尺寸1200x800
巨红细胞(直径>15um),大红细胞(直径10-15um).
图片尺寸328x253
外周血中不同细胞的形态图片鉴定 红细胞大小不等,见大红细胞.
图片尺寸1080x810
a, 小红细胞 b, 正红细胞 c, 大红细胞 d, 镰形红细胞 e, 球形红细胞
图片尺寸377x251
巨红细胞(直径>15um),大红细胞(直径10-15um).
图片尺寸404x264